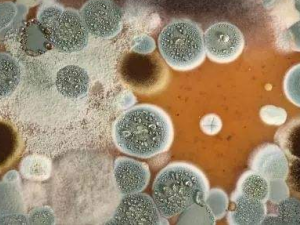
ë���Ӿ�������Щ֢״ ë���Ӿ���������ƫ��

男人如何保养头发?正确洗发的步骤
来源:互联网 时间:2017-12-09 09:05 编辑:admin 手机版访问
导读:洗头时总是很容易掉发,这是什麼原因?其实最重要是观察发量有无减少的倾向,因为掉发的原因有40种以上之多。...
洗头时总是很容易掉发,这是什麼原因?其实最重要是观察发量有无减少的倾向,因为掉发的原因有40种以上之多,在没有经过专家确认找出真正原因前,可千万不要自行推测想办法或随便乱擦东西,以免掉发更加严重。至於正确洗发的步骤如下:
1、先用温水充份冲湿头皮及头发。
2、选择适合自己头皮的洗发精,取适量在手心,搓揉起泡后在放到头上用指腹轻轻按摩头皮之后用温水冲净。

3、如果头发较乾躁,可取适量润发乳或护发乳,均匀擦在发尾处,停留数分后再洗净。
4、洗头后用毛巾轻拍头发,最好自然风乾,或用低温的吹风机,距离十公分以上吹乾。
你是否经常有头皮发痒,甚至才刚洗完头不久又会痒,就算常洗也无法解决的困扰吗?很多人遇到大量掉发时,都有头皮痒的经验。这时候光靠洗头当然是不能改善的,最根本的解决之道,应该及时寻求专家协助,否则您可能马上就要面临秃发的危机。
一时止痒不是办法
头皮痒是大量掉发的徵兆之一,一般人常常忽略了头皮痒的严重性,以为是头发脏了,洗洗头就没事,即使是使用薄荷配方的洗发精,也只是一时的舒爽,而不是治本的办法。只有找出头皮痒的原因,彻底改善头皮健康,才能完全消除头皮痒。
热点排行
-
 人到中年性福最重要 中老年性保健秘诀 性能力是可以提高的,下面是一套中老年性保健秘籍,主要根据中老年男性功能 … [详情]
人到中年性福最重要 中老年性保健秘诀 性能力是可以提高的,下面是一套中老年性保健秘籍,主要根据中老年男性功能 … [详情] -
 吃枣的好处?吃枣要牢记6大宜5大忌 冬天很多女性都气血俩虚,需要进补,而红枣便是最好的进补食材。可是吃枣也 … [详情]
吃枣的好处?吃枣要牢记6大宜5大忌 冬天很多女性都气血俩虚,需要进补,而红枣便是最好的进补食材。可是吃枣也 … [详情] -
 从手像看健康 老中医教你自测全身健康 手相如何看你的身体健康?相由身生,相随身变每个人的内心都会彰显于外。身 … [详情]
从手像看健康 老中医教你自测全身健康 手相如何看你的身体健康?相由身生,相随身变每个人的内心都会彰显于外。身 … [详情] -
 女人床上功夫好不好 看这六大表现就可知道 在性生活中,高质量的性生活是与男女之间默契的配合密切相关的,而女性朋友 … [详情]
女人床上功夫好不好 看这六大表现就可知道 在性生活中,高质量的性生活是与男女之间默契的配合密切相关的,而女性朋友 … [详情] -
 裸睡适合老年人吗 裸睡的好处 睡衣不宜过厚,即使是冬天,也应以轻薄柔软为佳。过厚的睡衣穿着不舒适,且 … [详情]
裸睡适合老年人吗 裸睡的好处 睡衣不宜过厚,即使是冬天,也应以轻薄柔软为佳。过厚的睡衣穿着不舒适,且 … [详情]
热门推荐
好文阅读
-
毛孢子菌病有哪些症状 毛孢子菌病的治疗偏方 口服碘化钾有消化不良或恶心、呕吐、胃纳不佳等胃肠道反应时,可用碘化钠1g … [详情]
毛孢子菌病有哪些症状 毛孢子菌病的治疗偏方 口服碘化钾有消化不良或恶心、呕吐、胃纳不佳等胃肠道反应时,可用碘化钠1g … [详情] -
 鳝鱼的营养价值 鳝鱼的食用方法 鳝鱼是一种食材,营养价值丰富,能增进视力,促进皮膜的新陈代谢!不宜于狗 … [详情]
鳝鱼的营养价值 鳝鱼的食用方法 鳝鱼是一种食材,营养价值丰富,能增进视力,促进皮膜的新陈代谢!不宜于狗 … [详情] -
 蔻附丸的功效 蔻附丸主老人中气不足久泻不止 功用脏寒脾泻;及老人中气不足 久泻不止。 … [详情]
蔻附丸的功效 蔻附丸主老人中气不足久泻不止 功用脏寒脾泻;及老人中气不足 久泻不止。 … [详情] -
 吃完柿子不能吃啥 吃完柿子后的饮食禁忌 比如刚出锅的热菜、热汤、热水、热茶,这些温度较高的食物如果进入人体内后 … [详情]
吃完柿子不能吃啥 吃完柿子后的饮食禁忌 比如刚出锅的热菜、热汤、热水、热茶,这些温度较高的食物如果进入人体内后 … [详情] -
 香蒲的功效与作用 香蒲的植物形态 香蒲的功效与作用有哪些?香蒲是一种草本植物,可以入药,具有很多的功效与 … [详情]
香蒲的功效与作用 香蒲的植物形态 香蒲的功效与作用有哪些?香蒲是一种草本植物,可以入药,具有很多的功效与 … [详情]

















